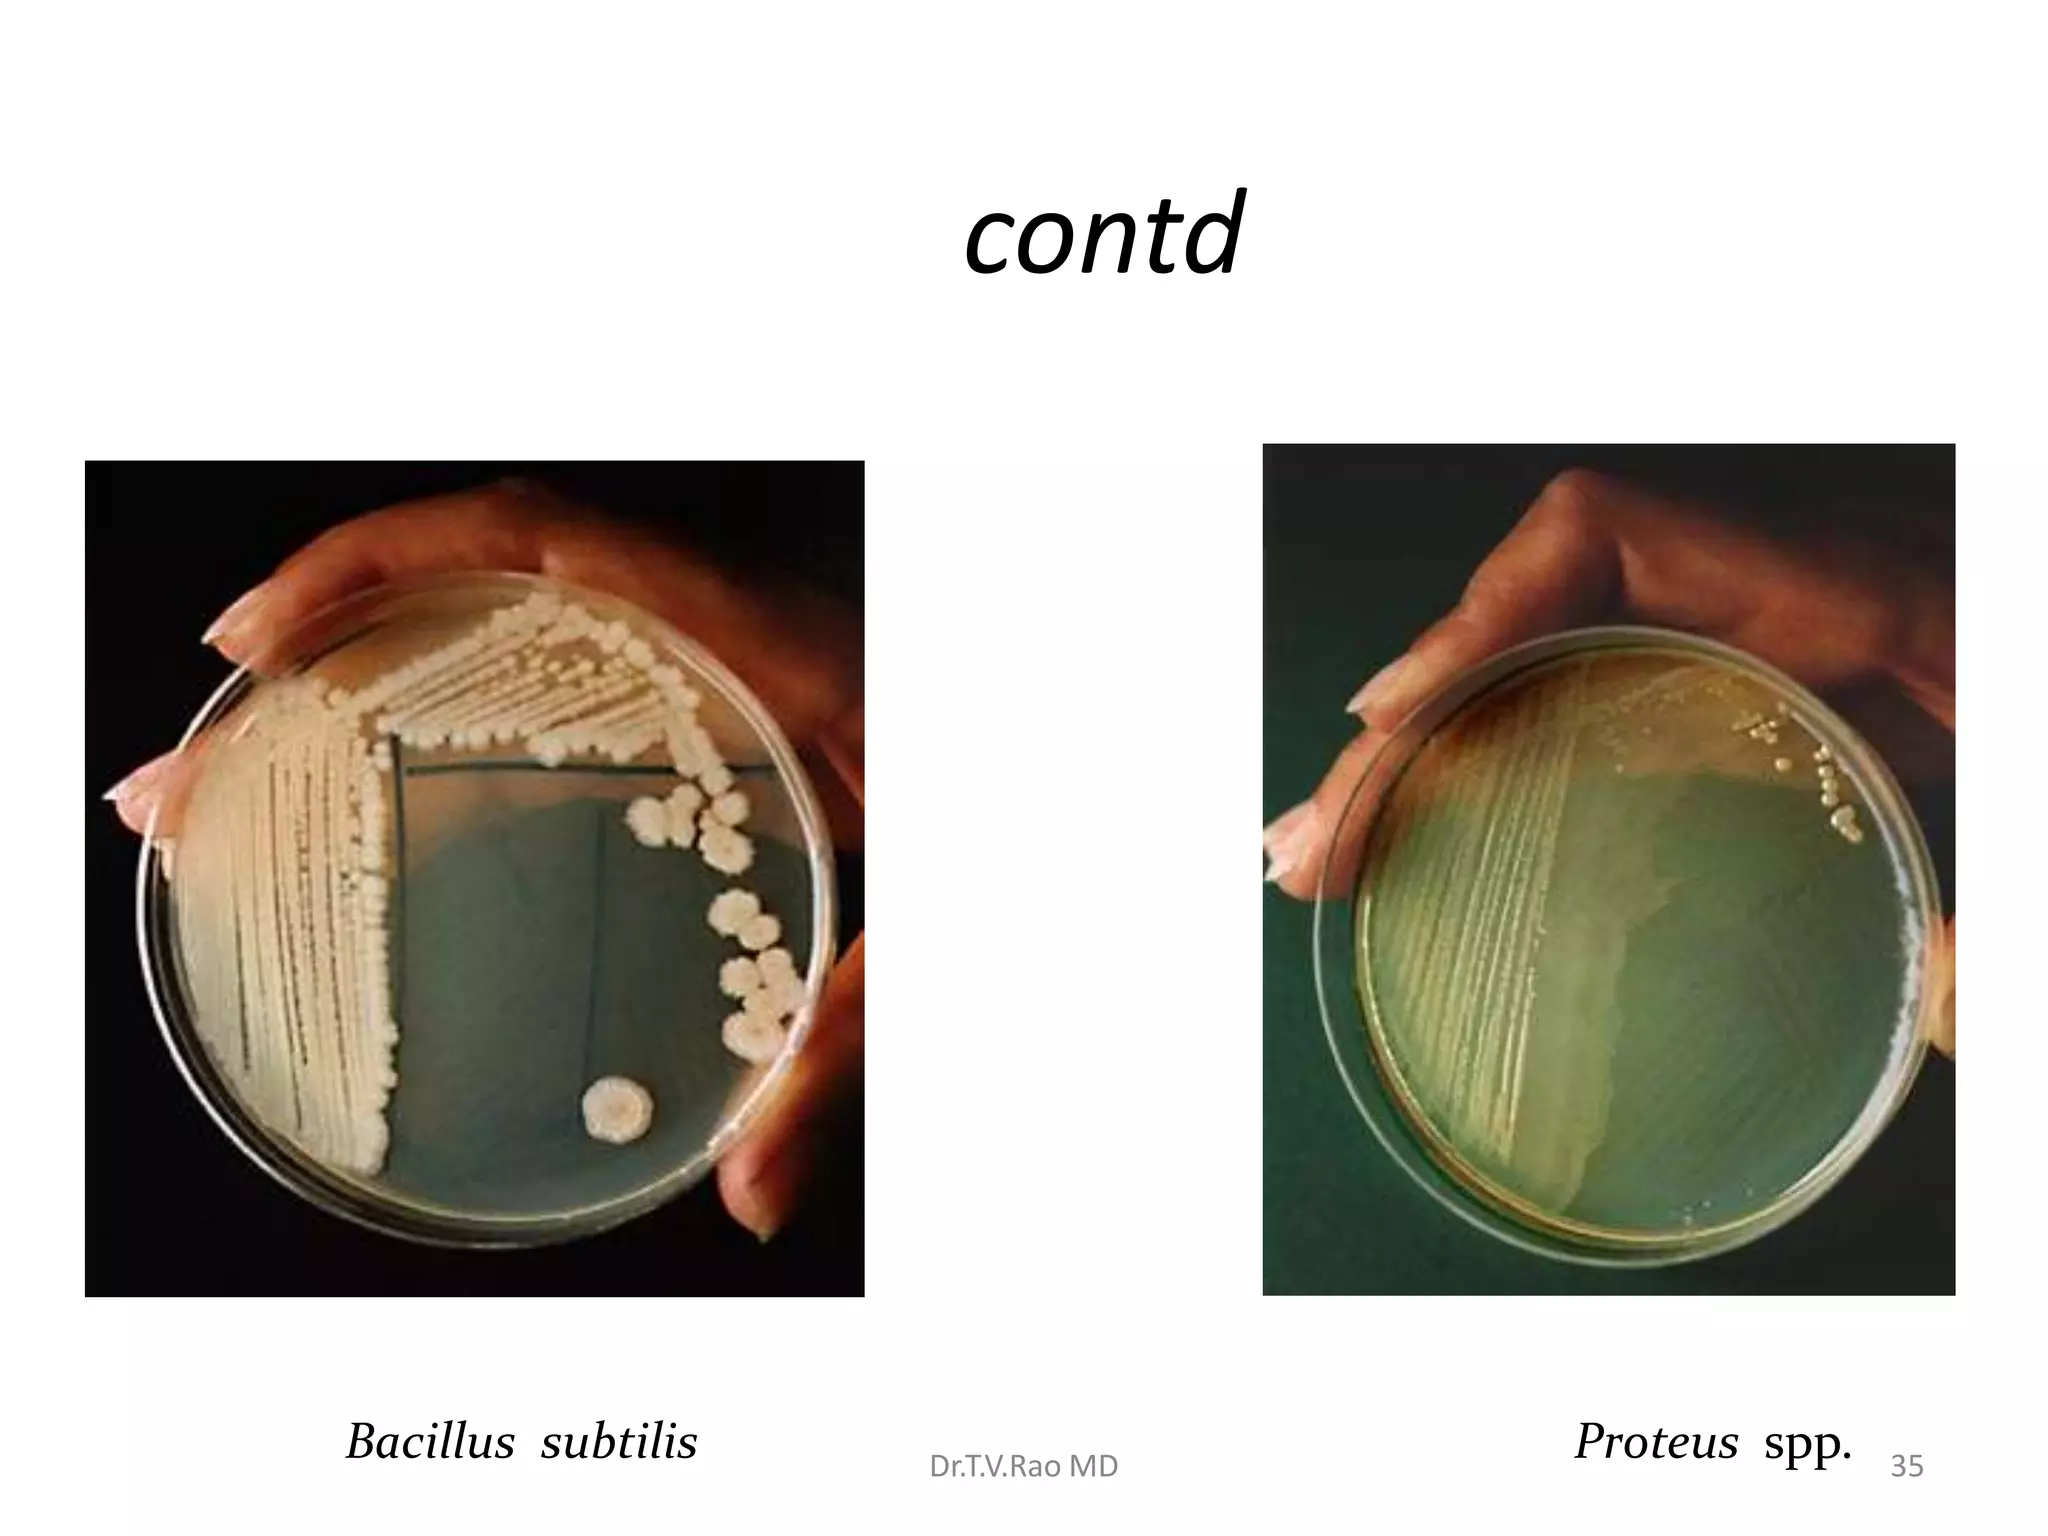
contd
Bacillus subtilis Proteus spp.
Dr.T.V.Rao MD 35
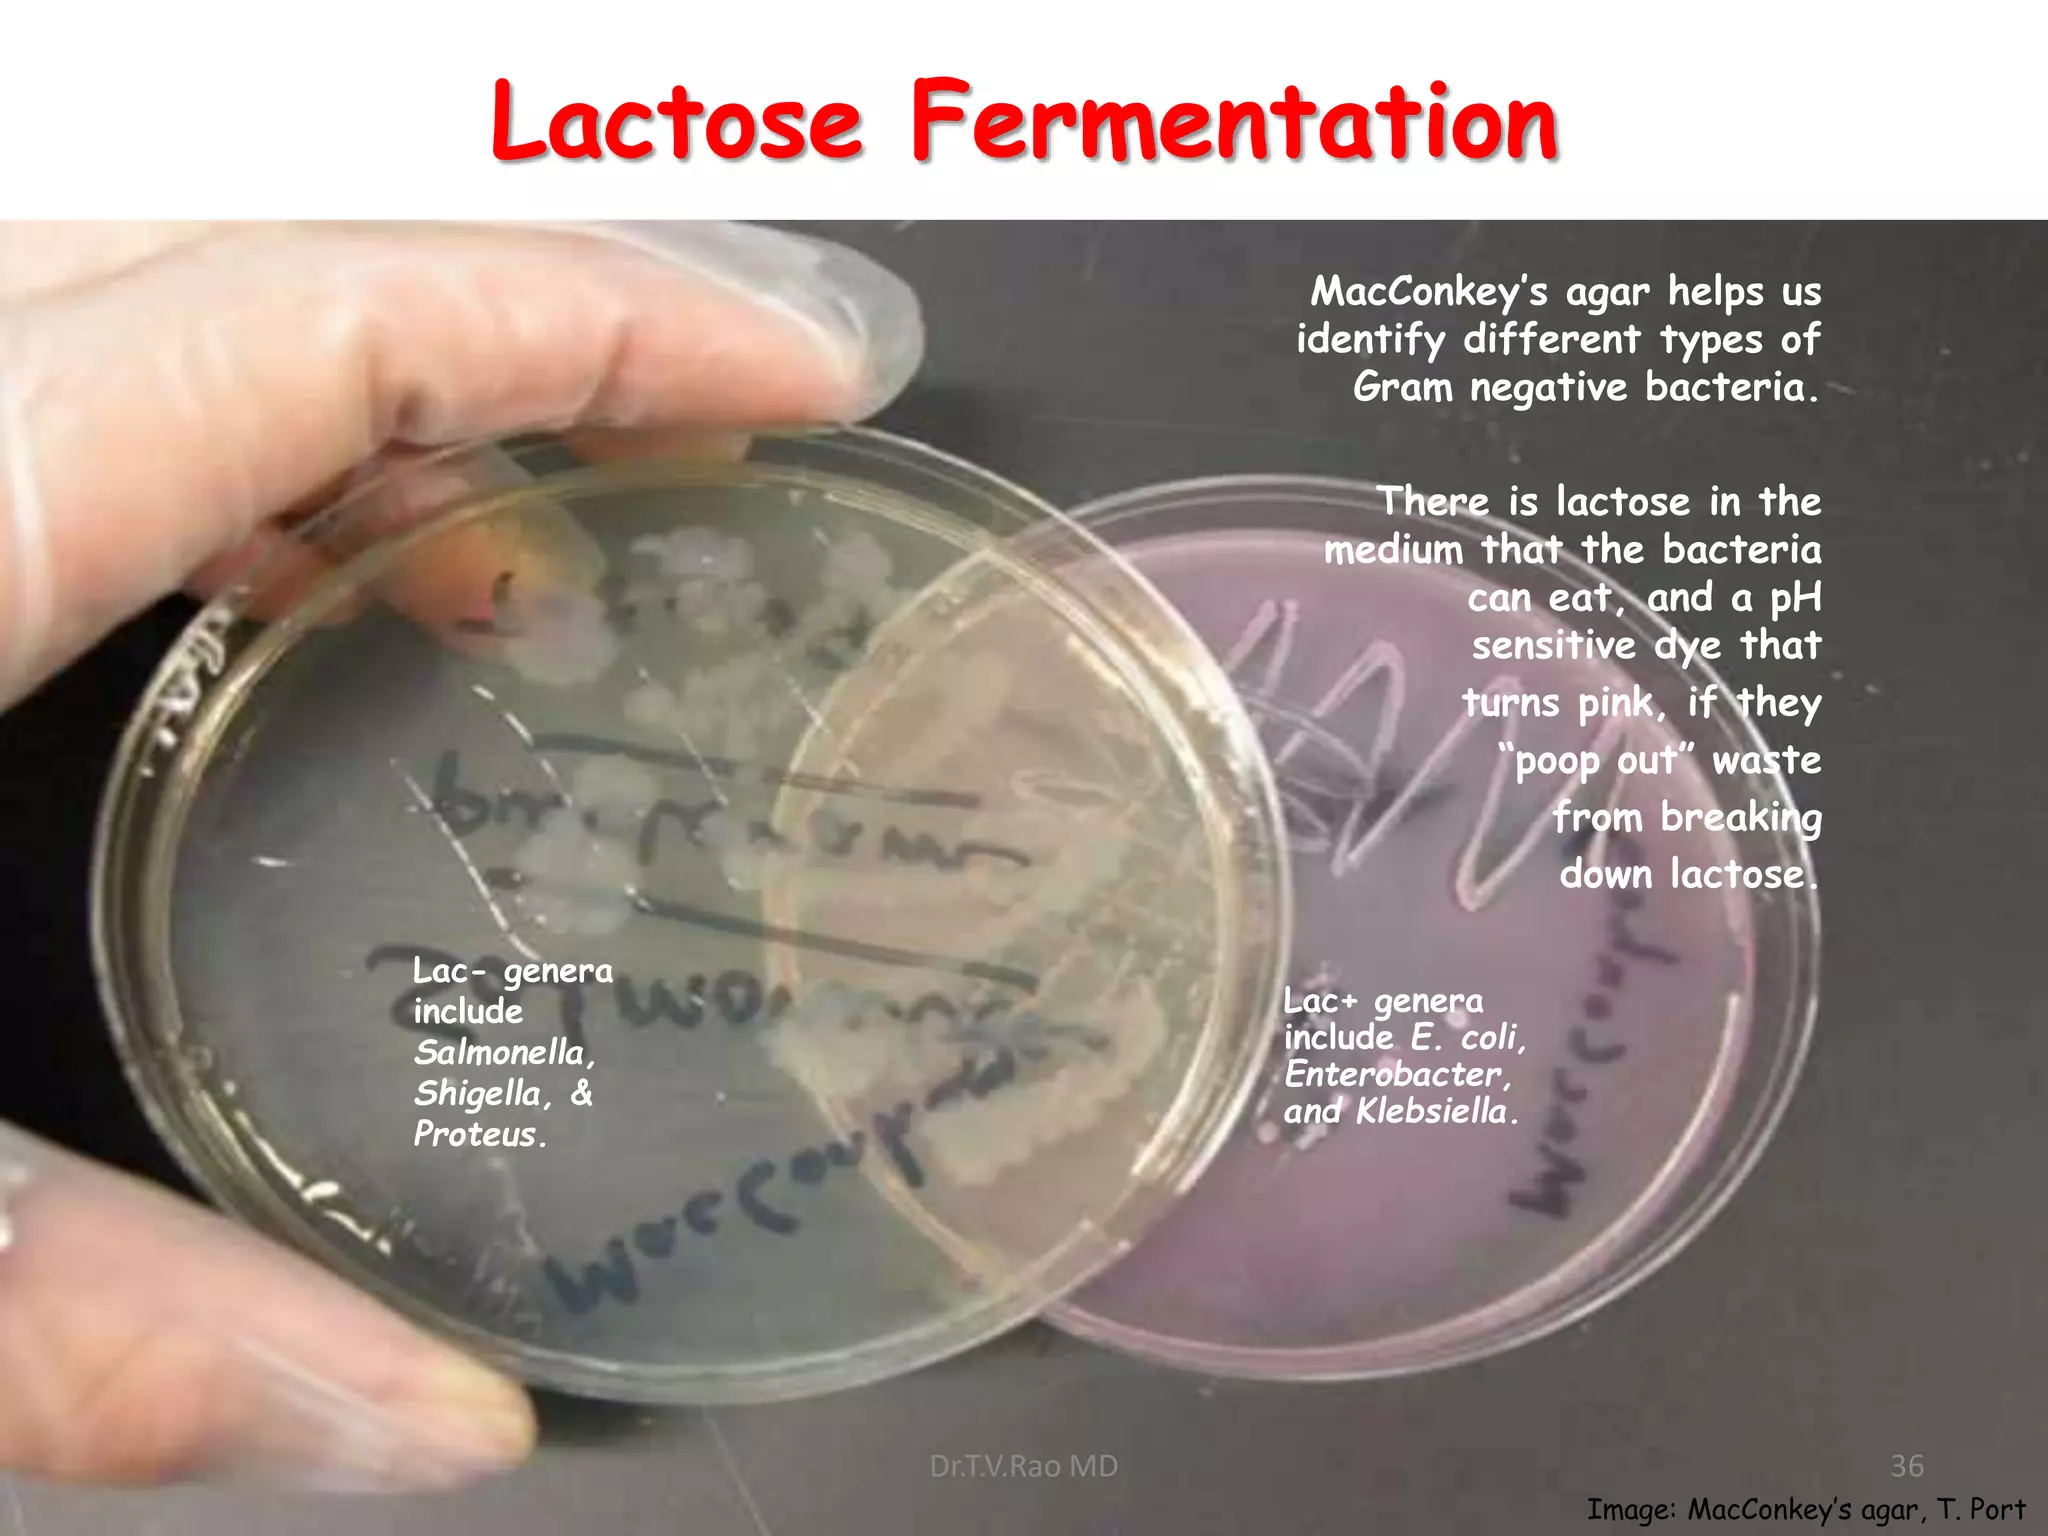
Lactose Fermentation
MacConkey’s agar helps us
identify different types of
Gram negative bacteria.
There is lactose in the
medium that the bacteria
can eat, and a pH
sensitive dye that
turns pink, if they
“poop out” waste
from breaking
down lactose.
Lac+ genera
include E. coli,
Enterobacter,
and Klebsiella.
Lac- genera
include
Salmonella,
Shigella, &
Proteus.
Image: MacConkey’s agar, T. Port
Dr.T.V.Rao MD 36

This document provides information on identifying bacteria. It discusses the hierarchy of biological classification and describes methods for bacterial identification including microscopic morphology, macroscopic morphology, physiological/biochemical characteristics, and genetic/molecular analysis. Steps for diagnostic isolation and identification are outlined beginning with streaking samples on culture plates and observing colony characteristics. Methods for examining bacterial cells like Gram stain, flagella, capsules, and spores are covered. Biochemical tests for identification like indole, methyl red, Voges-Proskauer, citrate, and lactose fermentation are also discussed.











![Gram stain
a. Gram stain divides the bacteria into Gram positive
& Gram negative.
The basic procedure :
i. Take a heat fixed bacterial smear.
ii. Flood the smear with CRYSTAL VIOLET or Methyl violet for 1
minute, then wash with water. [PRIMARY STAIN]
iii. Flood the smear with IODINE for 1 minute, then wash with water.
iv. Flood the smear with ETHANOL-ACETONE, quickly, then wash with
water. [DECOLORI
v. Flood the smear with SAFRANIN for 1 minute, then wash with
water. [COUNTERSTAIN]
vi. Blot the smear, air dry and observe.
Dr.T.V.Rao MD 12](https://image.slidesharecdn.com/identificationofbacteria-180120102225-211202091130/75/Identificationofbacteria-180120102225-12-2048.jpg)